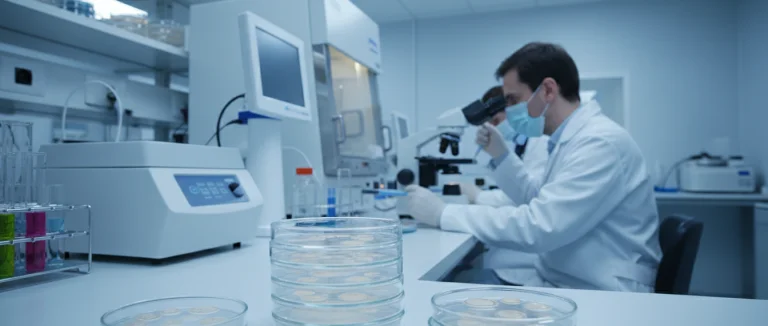
Исследования с эмбриональными клетками в лаборатории

Эмбриональные клетки: основы стволовой терапии Лив Хоспитал
-
Что такое эмбриональные клетки и их уникальные свойства
-
Отличия эмбриональных и взрослых стволовых клеток
-
Применение эмбриональных клеток в современной медицине
-
Этические и правовые аспекты исследований эмбриональных клеток
-
Будущее эмбриональных клеток: исследования и клинические испытания
-
Почему выбирают Лив Хоспитал
Эмбриональные клетки представляют собой уникальный тип стволовых клеток, способный дифференцироваться во все типы тканей организма. В последние годы их потенциал в стволовой терапии привлекает внимание ученых и врачей по всему миру. По оценкам экспертов, более 80 % клинических исследований в области регенеративной медицины используют именно эти клетки, что подчеркивает их значимость.
В этой статье мы разберём, что такое эмбриональные клетки, какие свойства их отличают от взрослых стволовых клеток, где они уже применяются в клинической практике и какие этические вопросы сопровождают их исследование. Вы получите полное представление о том, как эти клетки могут изменить будущее медицины и какие возможности они открывают для пациентов, ищущих инновационные методы лечения.
Если вы интересуетесь передовыми методами восстановления тканей, регенеративной медициной или планируете лечение в Лив Хоспитал, эта информация поможет вам понять, насколько перспективна терапия с использованием эмбриональных клеток.
Что такое эмбриональные клетки и их уникальные свойства

Эмбриональные клетки — это плюрипотентные стволовые клетки, получаемые из внутренней клеточной массы ранних эмбрионов (обычно на стадии бластоцисты). Их главная особенность — способность превращаться в любой тип клеток человеческого организма, от нейронов до кардиомиоцитов.
Эти клетки обладают высокой пролиферативной активностью, что позволяет выращивать их в лабораторных условиях в больших количествах. Благодаря своей гибкости, эмбриональные клетки являются фундаментом для разработки новых методов клеточной терапии и регенеративных процедур.
| Свойство | Эмбриональные клетки | Взрослые стволовые клетки |
|---|---|---|
| Потенциал дифференциации | Плюрипотентный (все типы тканей) | Мультипотентный (ограниченный набор тканей) |
| Пролиферативность | Высокая, легко расширяется | Низкая, требует специальных условий |
| Источники получения | Эмбрионы на ранней стадии развития | Костный мозг, кровь, жировая ткань |
Отличия эмбриональных и взрослых стволовых клеток

Хотя обе группы клеток используют в регенеративной медицине, их биологические характеристики существенно различаются.
- Потенциал дифференциации: эмбриональные клетки могут стать любой клеткой организма, тогда как взрослые ограничены определёнными линиями.
- Этические вопросы: получение эмбриональных клеток связано с использованием человеческих эмбрионов, что вызывает общественные дискуссии.
- Риск опухолевого роста: из‑за высокой пластиности эмбриональные клетки могут образовывать опухоли, если их неправильно контролировать.
- Терапевтическая эффективность: в некоторых моделях заболеваний эмбриональные клетки демонстрируют более быстрый и полноценный восстановительный эффект.
Применение эмбриональных клеток в современной медицине
В последние годы эмбриональные клетки нашли применение в ряде клинических направлений, где традиционные методы лечения оказываются недостаточными.
- Нейродегенеративные заболевания: исследования показывают, что трансплантация эмбриональных нейрональных предшественников может замедлить прогрессирование болезни Паркинсона.
- Сердечно-сосудистые патологии: дифференцированные в кардиомиоциты клетки используются для восстановления повреждённого миокарда после инфаркта.
- Терапия диабета: создание инсулин-продуцирующих бета‑клеток из эмбриональных стволовых клеток открывает перспективы для лечения типа 1 диабета.
- Офтальмология: эмбриональные клетки успешно применяются для регенерации сетчатки при возрастной макулярной дегенерации.
Этические и правовые аспекты исследований эмбриональных клеток
Исследования эмбриональных клеток находятся под строгим контролем международных и национальных регуляторов. Основные принципы включают:
- Получение эмбрионов только с информированного согласия доноров.
- Ограничение использования эмбрионов, полученных в результате вспомогательных репродуктивных технологий, которые не планируются к имплантации.
- Обеспечение прозрачности исследований и публикация результатов в открытом доступе.
- Соблюдение национального законодательства, которое в разных странах может варьироваться от полного запрета до разрешения под строгим надзором.
В Турции, где находится Лив Хоспитал, законодательство допускает проведение исследований с эмбриональными стволовыми клетками при условии соблюдения этических протоколов и получения одобрения этических комитетов.
Будущее эмбриональных клеток: исследования и клинические испытания
Развитие технологий CRISPR и геномного редактирования открывает новые горизонты для использования эмбриональных клеток. Учёные уже работают над созданием «исправленных» линий стволовых клеток, которые могут быть безопаснее для трансплантации.
Ключевые направления будущих исследований включают:
- Разработку методов безопасного внедрения дифференцированных клеток без риска опухолевого роста.
- Создание персонализированных терапий, где эмбриональные клетки модифицируются под конкретный генетический профиль пациента.
- Исследования в области иммунной совместимости, позволяющие избежать отторжения трансплантатов.
- Расширение клинических испытаний в областях, где пока нет эффективных методов лечения, например, спинальная мышечная атрофия.
Почему выбирают Лив Хоспитал
Лив Хоспитал — международный центр медицинского обслуживания в Стамбуле, аккредитованный JCI. Мы предлагаем комплексные программы терапии стволовыми клетками, включая работу с эмбриональными и мезенхимальными стволовыми клетками. Для иностранных пациентов обеспечивается полная поддержка: запись на приём, трансфер, услуги переводчика и помощь с размещением. Наша команда сочетает передовые научные исследования и клиническую практику, гарантируя высокий уровень безопасности и эффективности лечения.
Готовы узнать, как эмбриональные клетки могут изменить ваш путь к здоровью? Свяжитесь с нашими специалистами уже сегодня, чтобы получить индивидуальную консультацию и оформить запись на приём в Лив Хоспитал.
Часто задаваемые вопросы
Эмбриональные клетки извлекаются из ранних эмбрионов на стадии бластоцисты и обладают способностью дифференцироваться во все типы тканей организма. Благодаря высокой пролиферативной активности их можно выращивать в лаборатории в больших количествах. Это делает их фундаментом для разработки новых методов клеточной и регенеративной терапии, позволяя создавать нейроны, кардиомиоциты, бета‑клетки и другие специализированные клетки.
Эмбриональные стволовые клетки способны дифференцировать в любой тип клеток организма, что называется плюрипотентностью. Взрослые стволовые клетки, такие как мезенхимальные или гемопоэтические, обладают мультипотентностью — они могут образовывать лишь ограниченный набор клеток, характерных для их ткани происхождения. Кроме того, эмбриональные клетки имеют более высокую пролиферативность, но сопряжены с более высоким риском опухолевого роста и этическими вопросами, связанными с использованием человеческих эмбрионов.
Исследования показывают, что трансплантация эмбриональных нейрональных предшественников может замедлить прогрессирование болезни Паркинсона. Дифференцированные в кардиомиоциты клетки используют для восстановления миокарда после инфаркта. Создание инсулин‑продуцирующих бета‑клеток открывает перспективы лечения типа 1 диабета, а эмбриональные клетки применяются для регенерации сетчатки при возрастной макулярной дегенерации. Эти направления находятся в разных стадиях клинических испытаний.
Эмбриональные клетки получают из эмбрионов, созданных в рамках вспомогательных репродуктивных технологий. Основные этические вопросы включают согласие доноров, использование эмбрионов, которые не планируются к имплантации, и потенциальную коммерциализацию человеческой жизни. Международные и национальные регуляторы требуют прозрачности, публикации результатов и строгого контроля, чтобы минимизировать злоупотребления. В Турции, где расположен Лив Хоспитал, исследования разрешены при соблюдении этических протоколов и одобрения комитетов.
Технологии геномного редактирования, такие как CRISPR, позволяют создавать «исправленные» линии эмбриональных стволовых клеток с пониженным риском опухолевого роста. Будущее включает разработку методов безопасного внедрения дифференцированных клеток, персонализированных терапий, адаптированных под генетический профиль пациента, и улучшение иммунной совместимости, чтобы избежать отторжения. Кроме того, расширяются клинические испытания в областях, где пока нет эффективных методов лечения, например, спинальная мышечная атрофия, что открывает новые горизонты для регенеративной медицины.
* Содержимое нашего сайта предназначено только для информационных целей. Обязательно обратитесь к врачу для диагностики и лечения. В содержание страницы не включены элементы, содержащие информацию о терапевтических медицинских услугах в Лив Госпитале.